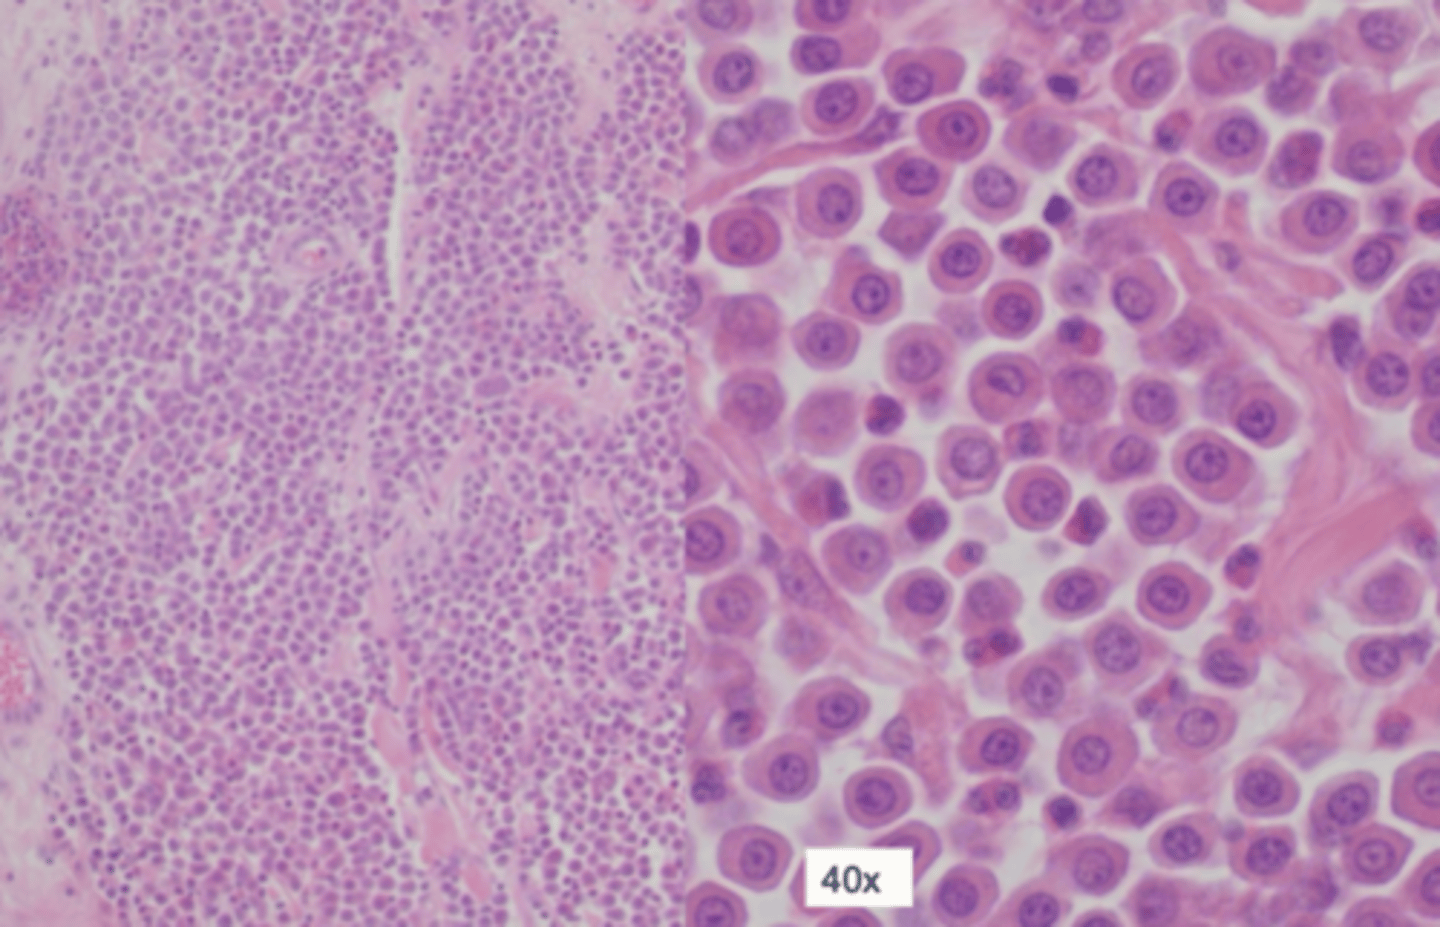
<p>Case 1 - Histopathology</p><p>why would you send this for histo?</p>

Cytology and histological correlation
1/21
There's no tags or description
Looks like no tags are added yet.
Name | Mastery | Learn | Test | Matching | Spaced | Call with Kai |
|---|
No analytics yet
Send a link to your students to track their progress
22 Terms
what do epithelial cells look like on cytology and biopsy
- found in - glandular and parenchymal tissues or lining surfaces (mammary gland, liver)
- high cell harvest
- cohesive aggregates
- cell borders distinct - grout lines, tight junctions
see junctions as white
- polygonal shaped cells, round nuclei
what can cytology/ histopathology tell us
inflam
non inflam
what can inflam be
septic
sterile
what can non inflam be
cystic
hyperplastic/ dysplastic
neoplastic
what neoplastic cell types are these


what 3 cell types can neoplastic be
round
mesenchymal
epithelial

What cell type are these
mesenchymal

What cell type are these
epithelial cells

What cell type are these
round cells
what do mesenchymal cells look like on cytology and biopsy
- found in - connective tissue, muscle, bone, cartilage, nerve, endothelial cells
- low cell harvest
- non-cohesive aggregates of individual
- cell borders variable defined, indistinct - wispy
- embedded in matrix
- splindle shaped, cytoplasmic tail
- oval or plump nuclei
what do round cells look like on cytology and biopsy
- 4 diff types
- high cell harvest
- individual cells
- round ish shape
- round or oval nuclei
- look at nuclear:cytoplasmic ration, position of nucleus → distinguish type
what are the 4 types of round cells
lymphocyte, plasma cells, mast cells, histiocyte/ macrophage


Case 1
describe this mass
Cutaneous mass on dorsum
well demarcated, raised, firm, round

Case 1 - Cytology
1. how populated with cells is this image
2. how are cells distributed/ what pattern
3. what is the shape of these cells
4. what cell category
5. what type of cell are they
1. high cell harvest
2. individually
3. round
4. round cell
5. mast cell
why use histopathology after cytopathology confirms cell type?
to grade the tissue and know if metastatic
Case 1 - Histopathology
why would you send this for histo?
highlight mast cell granules - special stain (toluidine blue)

Case 2
describe this mass, what is it likely to be
cutaneous interscapular mass
well demarcated, raised, firm, pale, ulcerated
injection site sarcoma

Case 2 - Cytology
1. what is the cell harvest
2. how are the cells distributed
3. what are the shape of these cells
4. what cell type are they
1. low
2. small cohesive aggregates and individual
3. spindle shaped
4. mesenchymal
is a giant mulinucleated cell on the r

Case 2 histopathology - why would we send this off for histo?
need to send most mesenchymal masses to understand whether they are bening or malignant

Case 3
describe this mass
(cutaneous mass on left next)
well demarcated, firm, round, ulcerated epidermis

Case 3 Cytology
1. what is the cell harvest
2. how are the cells distributed
3. what shape are these cells
4. what cell type are they
1. high
2. cohesive clusters - clear borders
3. polygonal
4. epithelial
Benign trichoblastoma

Case 3 Histopathology
why would you send this ?
location, species, work out if its benign or not